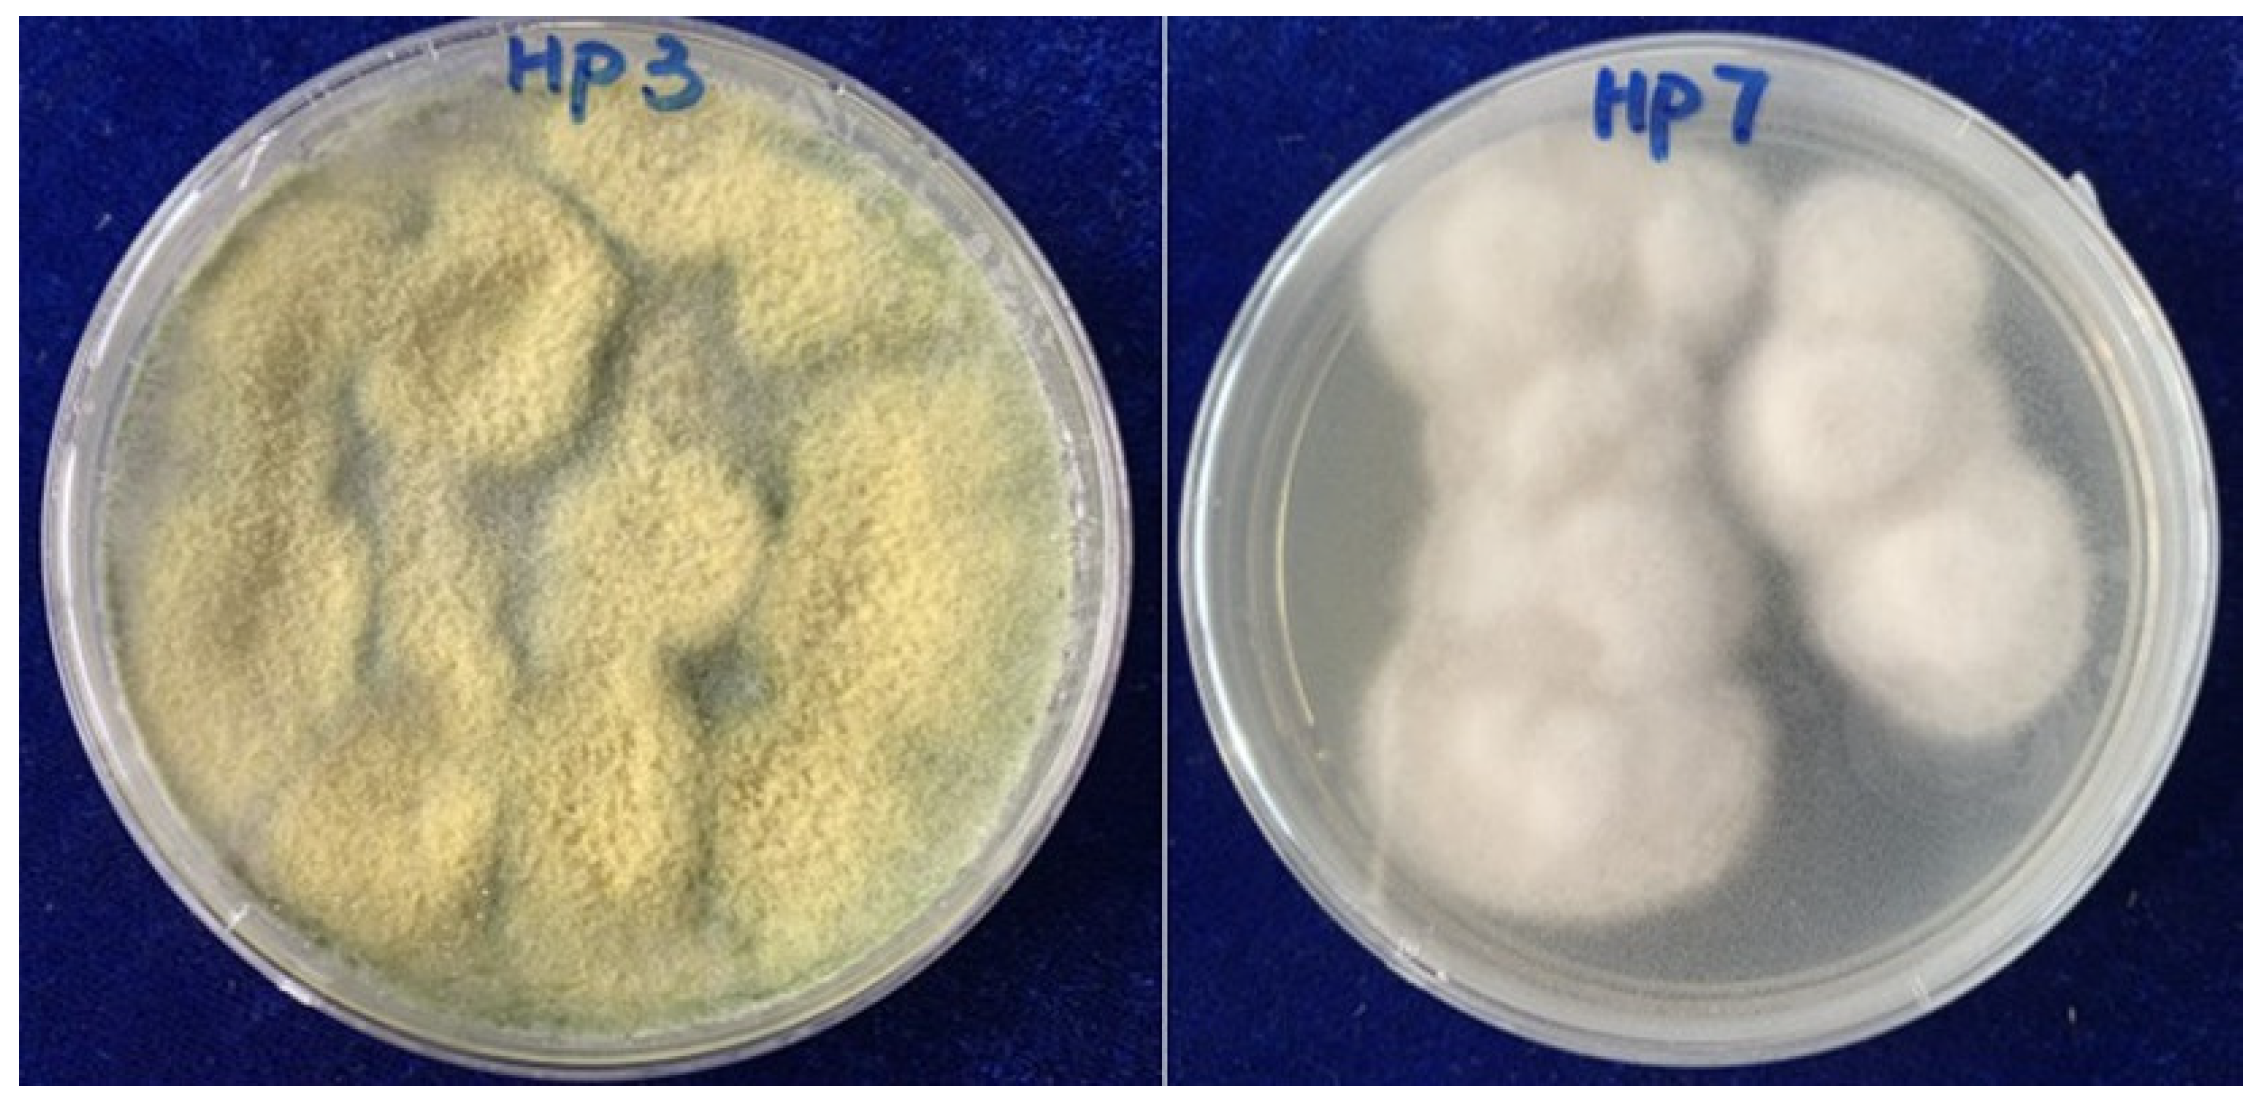

Two New Compounds from the Endophytic Fungi of Dryopteris crassirhizoma and Their Antimicrobial Activities
Abstract
:1. Introduction
2. Results and Discussion
2.1. Structure Elucidation of the Isolated Compounds
2.2. Antifungal Activity of the Isolated Compounds
2.3. Antibacterial Activity of the Isolated Compounds
3. Materials and Methods
3.1. Fermentation, Extraction, and Isolation
3.2. Assay of Anti-Plant Pathogenic Fungi Activity
3.3. Assay of Antibacterial Activity In Vitro
4. Conclusions
Supplementary Materials
Author Contributions
Funding
Institutional Review Board Statement
Informed Consent Statement
Data Availability Statement
Conflicts of Interest
References
- Jia, M.; Chen, L.; Xin, H.L.; Zheng, C.J.; Rahman, K.; Han, T.; Qin, L.P. A friendly relationship between endophytic fungi and medicinal plants: A systematic review. Front. Microbiol. 2016, 7, 1–14. [Google Scholar] [CrossRef]
- Kusari, S.; Hertweck, C.; Spitellert, M. Chemical ecology of endophytic fungi: Origins of secondary metabolites. Chem. Biol. 2012, 19, 792–798. [Google Scholar] [CrossRef]
- Eyberger, A.L.; Dondapati, R.; Porter, J.R. Endophyte fungal isolates from Podophyllum peltatum produce podophyllotoxin. J. Nat. Prod. 2006, 69, 1121–1124. [Google Scholar] [CrossRef]
- Deshmukh, S.K.; Dufosse, L.; Chhipa, H.; Saxena, S.; Mahajan, G.B.; Gupta, M.K. Fungal endophytes: A potential source of antibacterial compounds. Journal of Fungi 2022, 8, 164. [Google Scholar] [CrossRef]
- Yim, N.H.; Lee, J.J.; Lee, B.; Li, W.; Ma, J.Y. Antiplatelet activity of acylphloroglucinol derivatives isolated from Dryopteris crassirhizoma. Molecules 2019, 24, 2212. [Google Scholar] [CrossRef] [PubMed]
- Shepherd, J.A.; Poon, W.W.; Myles, D.C.; Clarke, C.F. The biosynthesis of ubiquinone: Synthesis and enzymatic modification of biosynthetic precursors. Tetrahedron Lett. 1996, 37, 2395–2398. [Google Scholar] [CrossRef]
- Chen, B.; Yin, H.-F.; Wang, Z.-S.; Xu, J.-H. New synthesis of harzialactone A via kinetic resolution using recombinant Fusarium proliferatum lactonase. Tetrahedron-Asymmetry 2010, 21, 237–240. [Google Scholar] [CrossRef]
- Shen, C.C.; Syu, W.J.; Li, S.Y.; Lin, C.H.; Lee, G.H.; Sun, C.M. Antimicrobial activities of naphthazarins from Arnebia euchroma. J. Nat. Prod. 2002, 65, 1857–1862. [Google Scholar] [CrossRef] [PubMed]
- Fujimoto, H.; Nakamura, E.; Okuyama, E.; Ishibashi, M. Six immunosuppressive features from an Ascomycete, Zopfiella longicaudata, found in a screening study monitored by immunomodulatory activity. Chem. Pharm. Bull. 2004, 52, 1005–1008. [Google Scholar] [CrossRef]
- Hybelbauerova, S.; Sejbal, J.; Dracinsky, M.; Hahnova, A.; Koutek, B. Chemical constituents of Stereum subtomentosum and two other birch-associated basidiomycetes: An interspecies comparative study. Chem. Biodivers. 2008, 5, 743–750. [Google Scholar] [CrossRef]
- Lin, Y.C.; Shao, Z.Y.; Jiang, G.C.; Zhou, S.N.; Cai, J.W.; Vrijmoed, L.L.P.; Jones, E.B.G. Penicillazine, a unique quinolone derivative with 4H-5,6-dihydro-1,2-oxazine ring system from the marine fungus Penicillium sp (strain #386) from the South China Sea. Tetrahedron 2000, 56, 9607–9609. [Google Scholar] [CrossRef]
- Dickinson, J.M.; Hanson, J.R.; Hitchcock, P.B.; Claydon, N. Structure and biosynthesis of harzianopyridone, an antifungal metabolite of Trichoderma harzianum. J. Chem. Soc. Perkin Trans. 1989, 1, 1885–1887. [Google Scholar] [CrossRef]
- Takenaka, Y.; Tanahashi, T.; Nagakura, N.; Hamada, N. 2,3-Dialkylchromones from mycobiont cultures of the lichen Graphis scripta. Heterocycles 2000, 53, 1589–1593. [Google Scholar] [CrossRef]
- Xie, X.Y.; Wang, R.; Shi, Y.P. Chemical constituents from rizomes of Homalomena occulta. Chin. J. Chin. Materia Med. 2013, 38, 2325–2327. [Google Scholar] [CrossRef]
- Shubina, L.K.; Makar’eva, T.N.; Denisenko, V.A.; Stonik, V.A. 4-hydroxybenzaldehyde from the baikal sponge Lubomirskia baicalensis. Chem. Nat. Compd. 2005, 41, 93–94. [Google Scholar] [CrossRef]
- Dieter, A.; Fiedler, H.P.; Goodfellow, M.; Muller, W.E.G.; Brun, R.; Beil, W.; Bringmann, G. Pyrocoll, an antibiotic, antiparasitic and antitumor compound produced by a novel alkaliphilic Streptomyces strain. J. Antibiot. 2003, 56, 639–646. [Google Scholar] [CrossRef] [PubMed]
- Cui, C.-M.; Li, X.M.; Li, C.S.; Proksch, P.; Wang, B.G. Cytoglobosins A-G, cytochalasans from a marine-derived endophytic fungus, Chaetomium globosum QEN-14. J. Nat. Prod. 2010, 73, 729–733. [Google Scholar] [CrossRef]
- Guo, Q.F.; Chen, L.; Yin, Z.-H.; Zhang, J.J.; Kang, W.Y.; Wang, X.W.; Ding, G. Secondary metabolites and α-glucosidase inhibitory activities of Chaetomium globosum H6. Mycosystema 2019, 38, 134–144. [Google Scholar] [CrossRef]
- Li, W.H.; Chang, S.T.; Chang, S.C.; Chang, H.T. Isolation of antibacterial diterpenoids from Cryptomeria japonica bark. Nat. Prod. Res. 2008, 22, 1085–1093. [Google Scholar] [CrossRef]
- Georges, P.; Sylvestre, M.; Ruegger, H.; Bourgeois, P. Ketosteroids and hydroxyketosteroids, minor metabolites of sugarcane wax. Steroids 2006, 71, 647–652. [Google Scholar] [CrossRef]
- Layne, T.H.; Reynolds, W.F.; McLean, S.; Tinto, W.F. Secondary metabolites from Clerodendrum chinense. Nat. Prod. Commun. 2008, 3, 1787–1792. [Google Scholar] [CrossRef]
- Piccialli, V.; Sica, D. Four new trihydroxylated sterols from the Sponge Spongionella gracilis. J. Nat. Prod. 1987, 50, 915–920. [Google Scholar] [CrossRef]
- Meng, X.; Mao, Z.; Lou, J.; Xu, L.; Zhong, L.; Peng, Y.; Zhou, L.; Wang, M. Benzopyranones from the endophytic fungus Hyalodendriella sp. ponipodef 12 and their bioactivities. Molecules 2012, 17, 11303–11314. [Google Scholar] [CrossRef]
- Yang, Z.J.; Yang, T.; Luo, M.Y.; Xia, X.; Chen, D.J.; Qian, X.P. A new sesquiterpenoid from fungus Colletotrichum sp. and its cytotoxicity. Acta Pharm. Sin. 2013, 48, 891–895. [Google Scholar]
- Li, X.; Tian, Y.; Dong, Q.; Geng, W.; Song, X.; Luo, D. The secondary metabolites of the endophytic fungi Pestalotiopsis versicolor from mangrove and their biological activities. Chin. Tradit. Pat. Med. 2019, 41, 1054–1058. [Google Scholar]
- Krohn, K.; Florke, U.; Rao, M.S.; Steingrover, K.; Aust, H.J.; Draeger, S.; Schulz, B. Metabolites from fungi 15. New isocoumarins from an endophytic fungus isolated from the Canadian thistle Cirsium arvense. Nat. Prod. Lett. 2001, 15, 353–361. [Google Scholar] [CrossRef] [PubMed]
- Zhao, W.; Xu, L.L.; Zhang, X.; Gong, X.W.; Zhu, D.L.; Xu, X.H.; Wang, F.; Yang, X.L. Three new phenanthrenes with antimicrobial activities from the aerial parts of Juncus effusus. Fitoterapia 2018, 130, 247–250. [Google Scholar] [CrossRef] [PubMed]
- Wu, X.; Fang, L.Z.; Liu, F.L.; Pang, X.J.; Qin, H.L.; Zhao, T.; Xu, L.L.; Yang, D.F.; Yang, X.L. New prenylxanthones, polyketide hemiterpenoid pigments from the endophytic fungus Emericella sp XL029 and their anti-agricultural pathogenic fungal and antibacterial activities. Rsc Advances 2017, 7, 31115–31122. [Google Scholar] [CrossRef]
- Li, H.Y.; Fu, T.T.; Zhang, Y.; Lv, T.Y.; Li, Y.; Xu, B.L. Effect comparison of five methods to extract fungal genomic DNA as PCR templates. Chinese Agric. Sci. Bull 2017, 33, 28–35. [Google Scholar]
- Shen, L.; Ju, J.J.; Liu, Q.; Wang, S.S.; Huang, W.Y. Antioxidative and neuroprotective effects of the cytochalasans from endophytes. Nat. Prod. Commun. 2020, 15, 1–7. [Google Scholar] [CrossRef]
- Gao, W.X.; He, Y.; Li, F.L.; Chai, C.W.; Zhang, J.W.; Guo, J.R.; Chen, C.M.; Wang, J.P.; Zhu, H.C.; Hua, Z.X.; et al. Antibacterial activity against drug-resistant microbial pathogens of cytochalasan alkaloids from the arthropod-associated fungus Chaetomium globosum TW1-1. Bioorg. Chem. 2019, 98, 98–104. [Google Scholar] [CrossRef] [PubMed]
- Ding, G.; Song, Y.C.; Chen, J.R.; Xu, C.; Tan, R.X. Chaetoglobosin U, a cytochalasan alkaloid from endophytic Chaetomium globosum IFB-E019. J. Nat. Prod. 2006, 69, 302–304. [Google Scholar] [CrossRef] [PubMed]
- Hua, C.; Yang, Y.; Sun, L.; Dou, H.; Tan, R.; Hou, Y. Chaetoglobosin F, a small molecule compound, possesses immunomodulatory properties on bone marrow-derived dendritic cells via TLR9 signaling pathway. Immunobiology 2013, 218, 292–302. [Google Scholar] [CrossRef]
- Zhu, X.W.; Wu, Z.H.; Liang, F.Y.; Gan, S.X.; Huang, Q.; Ding, W.J.; Li, C.Y. A new L-alanine derivative from the mangrove fungus Penicillium chrysogenum V11. Chem. Nat. Compd. 2018, 54, 520–522. [Google Scholar] [CrossRef]
- Li, H.; Xiao, J.; Gao, Y.Q.; Tang, J.J.; Zhang, A.L.; Gao, J.M. Chaetoglobosins from Chaetomium globosum, an endophytic fungus in Ginkgo biloba, and their phytotoxic and cytotoxic activities. J. Agric. Food Chem. 2014, 62, 3734–3741. [Google Scholar] [CrossRef]
- Andrew, J.F.; Amanda, I.B.; John, A.J.; Christopher, A.G. Polyketides from an endophytic Aspergillus fumigatus isolate inhibit the growth of Mycobacterium tuberculosis and MRSA. Nat. Prod. Commun. 2015, 10, 1661–1662. [Google Scholar] [CrossRef]

| 1 | 2 | ||||
|---|---|---|---|---|---|
| No. | δH (mult., J in Hz) | δC (mult.) | No. | δH (mult., J in Hz) | δC (mult.) |
| 1 | 101.6, C | 1 | 154.3, C | ||
| 2 | 157.8, C | 2 | 123.5, C | ||
| 3 | 115.6, C | 3 | 7.05, d, 7.6 | 130.9, CH | |
| 4 | 151.3, C | 4 | 6.84, t, 7.6 | 120.8, CH | |
| 5 | 139.8, C | 5 | 7.13, t, 7.6 | 128.2, CH | |
| 6 | 7.17, s | 107.8, CH | 6 | 6.80, d, 7.6 | 115.9, CH |
| 1′ | 3.41, d, 7.2 | 22.1, CH2 | 7 | 2.93, t, 6.7 | 29.9, CH2 |
| 2′ | 5.26, t, 7.2 | 121.3, CH | 8 | 4.29, t, 6.7 | 64.8, CH2 |
| 3′ | 135.9, C | 1′ | 133.6, C | ||
| 4′ | 1.93, 1.99, m | 39.8, CH2 | 2′ | 7.25, m | 129.3, CH |
| 5′ | 2.00, 2.06, m | 26.7, CH2 | 3′ | 7.31, m | 128.7, CH |
| 6′ | 5.07, overlapped | 124.2, CH | 4′ | 7.27, m | 127.2, CH |
| 7′ | 134.9, C | 5′ | 7.31, m | 128.7, CH | |
| 8′ | 1.93, 1.99, m | 39.7, CH2 | 6′ | 7.25, m | 129.3, CH |
| 9′ | 2.00, 2.06, m | 26.7, CH2 | 7′ | 3.64, s | 41.4, CH2 |
| 10′ | 5.07, overlapped | 124.4, CH | 8′ | 172.0, C | |
| 11′ | 134.9, C | ||||
| 12′ | 1.66, s | 25.7, CH3 | |||
| 13′ | 1.58, s | 17.7, CH3 | |||
| 14′ | 1.56, s | 16.0, CH3 | |||
| 15′ | 1.78, s | 16.2, CH3 | |||
| -OCH3 | 3.87, s | 56.3, CH3 | |||
Disclaimer/Publisher’s Note: The statements, opinions and data contained in all publications are solely those of the individual author(s) and contributor(s) and not of MDPI and/or the editor(s). MDPI and/or the editor(s) disclaim responsibility for any injury to people or property resulting from any ideas, methods, instructions or products referred to in the content. |
© 2023 by the authors. Licensee MDPI, Basel, Switzerland. This article is an open access article distributed under the terms and conditions of the Creative Commons Attribution (CC BY) license (https://creativecommons.org/licenses/by/4.0/).
Share and Cite
Hai, P.; Gao, Y.; Yang, L.; Chen, N.; Jia, H.; Wang, M.; Li, H.; Jiang, W.; Yang, J.; Li, R. Two New Compounds from the Endophytic Fungi of Dryopteris crassirhizoma and Their Antimicrobial Activities. Molecules 2023, 28, 8043. https://doi.org/10.3390/molecules28248043
Hai P, Gao Y, Yang L, Chen N, Jia H, Wang M, Li H, Jiang W, Yang J, Li R. Two New Compounds from the Endophytic Fungi of Dryopteris crassirhizoma and Their Antimicrobial Activities. Molecules. 2023; 28(24):8043. https://doi.org/10.3390/molecules28248043
Chicago/Turabian StyleHai, Ping, Yuan Gao, Lian Yang, Nie Chen, Haiyan Jia, Mengdie Wang, Huan Li, Wenli Jiang, Jian Yang, and Rongtao Li. 2023. "Two New Compounds from the Endophytic Fungi of Dryopteris crassirhizoma and Their Antimicrobial Activities" Molecules 28, no. 24: 8043. https://doi.org/10.3390/molecules28248043
APA StyleHai, P., Gao, Y., Yang, L., Chen, N., Jia, H., Wang, M., Li, H., Jiang, W., Yang, J., & Li, R. (2023). Two New Compounds from the Endophytic Fungi of Dryopteris crassirhizoma and Their Antimicrobial Activities. Molecules, 28(24), 8043. https://doi.org/10.3390/molecules28248043
